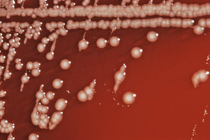

microbiology
There are microscopic organisms living all around us. Most do not cause people harm or concern, but some may cause allergies and infections, trigger asthma, or contaminate foods and products. Analyzing and testing for microorganisms is what the experts at LA Testing do better than anyone else.
LA Testing is a leading provider of everything from routine microbiological testing to advanced analysis using PCR and DNA testing techniques. The expert scientists and technicians regularly test water, air quality, soil, surfaces, dust, foods, consumer and cosmetic products, and other items for all types of microbiological contaminates.
In addition to providing services to the public, LA Testing works with countless companies and government agencies on projects of every size and scope. The QA/QC program at LA Testing ensures that all customers receive scientifically sound and legally defensible data.
In LA Testing’s network of laboratories, many of the microbiology laboratories maintain accreditation under the American Industrial Hygiene Association's Environmental Microbiology Laboratory Accreditation Program (AIHA EMLAP) for the analysis of indoor air quality samples. LA Testing's parent company EMSL Analytical, Inc. is pursuing advanced accreditation under the A2LA and FDA GMP/cGLP program for food, dietary supplements, nutraceutical and pharmaceutical analysis.
LA Testing also offers customized method development and special project design for non-routine analyses using ASTM, AOAC, FDA BAM, CTFA, USP, EPA, APHA, ASM as well as international testing methodologies. LA Testing’s internal QA/QC program is ISO 17025 compliant.
Some of the microbiology testing services offered by LA Testing include:
- Anthrax – Bacillus anthracis
- ARMI (American Relative Moldiness Index)
- Bacteria Identification (Culture, MIDI, BIOLOG, Biochemical tests, PCR)
- Bacteroides by PCR
- Bed bug identification by PCR
- Biofilm-Associated Bacteria (Group test: IRB, SRB, SLYME)
- Clostridium chauvoei by PCR
- Cryptococcus neoformans (PCR or Culture methods)
- Culturable Fungi (Air, Swab, Dust, or Bulk)
- Denitrifying Bacteria (DN)
- E. coli Detection by Colilert (Presence/Absence)
- E. coli Detection by Membrane Filtration
- Endotoxin Testing by Kinetic LAL
- Enteroviruses by PCR
- ERMI (Environmental Relative Moldiness Index)
- Fecal Coliform by Membrane Filtration
- Fecal Streptococcus by Membrane filtration
- Fungi by Direct Examination (Tape Lift, Bio-Tape, Bulk, or Swab)
- Gram Stain and Enumeration of Culturable Bacteria
- Helicobacter pylori by PCR
- Heterotrophic Plate Count
- Histoplasma capsulatum detection (PCR or culture method)
- Iron-related, Sulfate-reducing, and Slime-forming Bacteria
- Legionella Detection (CDC method or rapid PCR)
- Lyme Disease (Borrelia burgdorferi) detection by PCR
- Molecular Identification methods (PCR, Sequencing)
- MRSA (Methicillin-resistant Staphylococcus aureus)
- Mycobacteria Detection
- Mycotoxins
- Naegleria fowleri by PCR
- Nitrifying Bacteria (N)
- Pollen Identification and Enumeration
- Pseudomonas aeruginosa Detection
- Recreational Water Analysis (Total Coliform, Fecal Coliform, Staphylococcus, Fecal Streptococcus)
- Salmonella Detection and Enumeration
- Sewage Contamination in Buildings (Total Coliform, Fecal Coliform, E. coli, Fecal Streptococcus)
- Spore Traps (Total Fungal Spore Count, Pollen, Skin, Insect Fragments and Background Density)
- Total Coliform by Colilert (Presence/Absence)
- Total Coliform Count by Membrane Filtration
- Wood Rot Fungi Identification by PCR
Turn to the professionals at LA Testing for all of your microbiology testing needs. Contact LA Testing for a free quote.